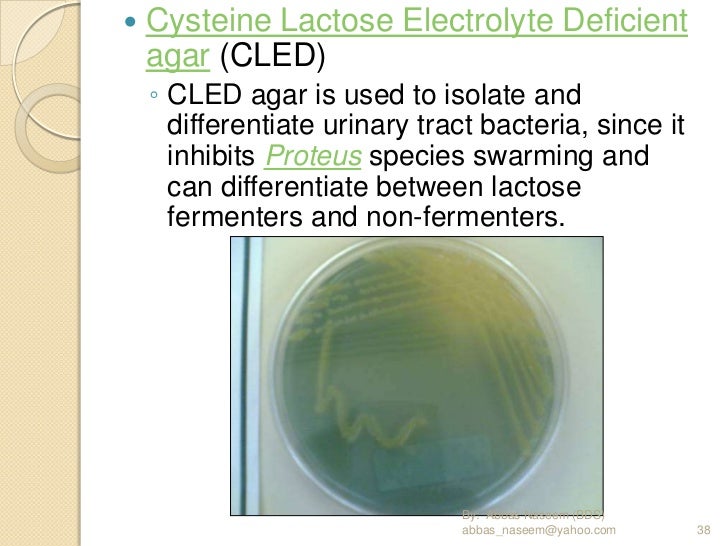
Pathology ospe revised edition

If you are searching about Kidney Disease in Dogs & Cats | Long Beach Animal Hospital you've came to the right web. We have 8 Pictures about Kidney Disease in Dogs & Cats | Long Beach Animal Hospital like How Do Bacteria Reproduce? | Sciencing, InPouch® TV Culture Media, Detect T. vaginalis from Clinical Specimens and also MacConkey Agar (MAC): Composition, preparation, uses and colony. Read more:
Kidney Disease In Dogs & Cats | Long Beach Animal Hospital
culture urine mic coli sensitivity escherichia organism heard stands many most
Oral Yeast Infection | RemoveYeastInfection.com
yeast infection candida albicans candidiasis oral fungus tag
Urethritis Laboratory Findings - Wikidoc
stain gram urethritis pmns laboratory findings discharge urethral wikidoc ngu wbc bacteria numerous intracellular note without
How Do Bacteria Reproduce? | Sciencing
 sciencing.com
sciencing.com bacteria reproduce getty istock replicate
Proteus Spp (2)
proteus mirabilis vulgaris
Pathology Ospe Revised Edition
www.slideshare.net
www.slideshare.net cled ospe revised lactose electrolyte deficient
MacConkey Agar (MAC): Composition, Preparation, Uses And Colony
agar macconkey colonies mac characteristics colony lactose non fermenting preparation bacteria gram negative composition positive coli fermenter colorless proteus fermenters
InPouch® TV Culture Media, Detect T. Vaginalis From Clinical Specimens
 www.calpaclab.com
www.calpaclab.com vaginalis trichomonas
How do bacteria reproduce?. Proteus spp (2). Macconkey agar (mac): composition, preparation, uses and colony